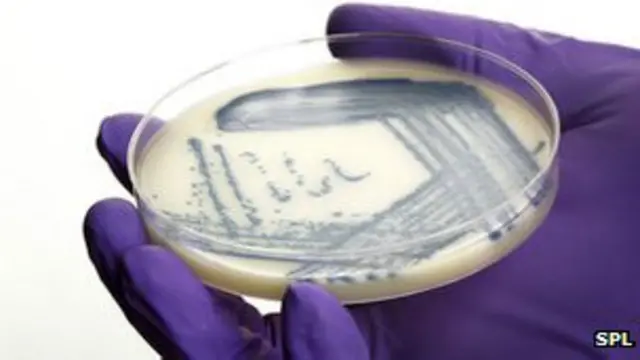
باکتری

راز دانش: مشاهده آینده احتمالی منظومه شمسی

در برنامه این هفته راز دانش که از برنامه بامدادی رادیو بی بی سی پخش شد به این خبرها پرداخته ایم: تصویری از آینده منظومه شمسی با بررسی دو منظومه دوردست پس از مرگ ستاره مرکزی آنها، استفاده از باکتری های معده برای مقابله با چاقی در حیوانات و خبری درباره اهمیت درختان منطقه آمازون در تولید انرژی.
آینده منظومه شمسی
اخترشناسان از قبل می دانستند که وقتی سوخت هسته ای خورشید تمام شد ابتدا متورم و در نهایت لایه های بیرونی اش منفجر و در فضا پخش می شود.
بعضی از سیارات نزدیک خورشید در این فرآیند بلعیده می شوند و سیارک هایی که میان سیارات نزدیک و دور می گردند از مدار خارج می شوند.
بنابراین اینکه چه سرنوشتی در انتظار منظومه شمسی بعد از مرگ خورشید است از قبل پیش بینی می شد.
حالا یک تیم محققان از دانشگاه کمبریج می گوید شواهدی از این تلاطم بزرگ را در اتمسفر دو ستاره پس از سوختن آنها دیده است.
این دو ستاره در خوشه قلائص یا به لاتین هایادیز در صورت فلکی برج ثور در فاصله تقریبا ۱۵۰ سال نوری از ما قرار دارند.
دو ستاره مورد نظر به اصطلاح کوتوله های سفید هستند یعنی همان چیزی که پس از سوختن ستاره های متوسط که بی شباهت به خورشید نیستند به جا می ماند.
منجمان با تلکسوپ فضایی هابل به بررسی این کوتوله ها پرداختند.
آنها با کمک طیف سنج قدرتمند این تلسکوپ موسوم به سرمنشا کیهان توانستند ترکیب شیمیایی این ستارگان را شناسایی کنند.
این نشان داد که کوتوله ها "آلوده" به سیلیکون هستند.
دکتر جی فریهی از موسسه نجوم کمبریج می گوید: "منظور از آلوده این است که موادی هست که به داخل آنها می افتد، ما شاهد سیلیکون و میزان کمی کربن در این ستارگان هستیم و اینها نباید آنجا باشند چون اگر مقداری از آن را روی این ستاره ها بریزید فورا در آن ته نشین می شوند یعنی به هسته می روند، بنابراین این واقعیت که این عناصر که از هیدروژن و هلیوم سنگین ترند وجود دارند به این معنی است که منبعی وجود دارد که ستارگان دائما از آنها تغذیه می کنند و در واقع حلقه ای هست که این مواد را راهی این ستارگان می کند و ترکیب سیلیکون به کربن آن هم مشخصا مثل اجرام سنگی منظومه شمسی است."
و وجود حلقه ای که دکتر فریهی به آن اشاره می کند هم از قبل پیش بینی می شد.
مدل های کامپیوتری نشان می دهد که با پیر شدن ستارگان و جدا شدن لایه های بیرونی شان، محیط اطراف بی ثبات می شود.
هر سیاره بزرگی در اطرافشان باشد شروع به پرت کردن تکه سنگ هایی می کند که بسیاری از آنها بر کوتوله سفید فرود می آید.
رصدهای هابل از خوشه قلائص به احتمال زیاد همین فرآیند را در عمل نشان می دهد.
و این تصویری از آینده احتمالی خورشید ماست.
آزمایش های میکروبی برای مقابله با چاقی
دانشمندان می گویند باکتری هایی که در معده وجود دارد برای مقابله با چاقی و دیابت نوع دو در حیوانات به کار گرفته شده اند.
این تحقیقات که نتایج آن در نشریه اقدامات آکادمی ملی علوم چاپ شده نشان داد که مایعی حاوی فقط یک گونه باکتری می تواند وضع موش چاق را تغییر دهد.
تصور می شود که این باکتری روکش معده و نحوه جذب غذا را تغییر می دهد.
اکنون تست های مشابه در انسان لازم است تا معلوم شود تاثیر این باکتری بر کاهش وزن چیست.
بدن انسان مملو از باکتری هاست؛ در واقع شمار این ارگانیسم های ریز ده برابر شمار سلول ها در بدن است.
و شواهد فزاینده ای وجود دارد از اینکه این مجموعه باکتری ها یا میکروب ها نقش مهمی در سلامت انسان بازی می کنند.
مثلا مطالعات نشان داده که تفاوت هایی میان انواع و شمار باکتری ها در معده افراد لاغر و چاق وجود دارد.
در همین حال معلوم شده که عمل های تنگ کردن دهانه معده – که برای کمک به کاهش وزن انجام می شود - توازن باکتری های معده را تغییر می دهد.
محققان در دانشگاه کاتولیک لووان بلژیک فقط یک نوع باکتری به نام آکِرمانسیا مونیسیفیلا را آزمایش کردند.
این باکتری معمولا ۳ تا ۵ درصد باکتری های معده را تشکیل می دهد اما میزان آن در افراد چاق افت می کند.
به موشی که غذای پرکالری می خورد و وزن اضافه کرد از این باکتری داده شد.
این موش ها نیمی از وزن اضافه خود را بدون هیچ تغییری در رژیم غذایی از دست دادند.
همچنین مقاومت انسولینی که از علائم اصلی دیابت نوع دو است در آنها کمتر بود.
پروفسور پاتریس کانی از اعضای تیم تحقیق گفت که هرچند آنها نتوانستند چربی اضافه شده را کاملا آب کنند اما کاهش میزان چربی بسیار قابل توجه بود.
این اولین بار است که نشان داده می شود رابطه مستقیمی میان گونه های مشخص باکتری و بهبود متابولیسم وجود دارد.
افزودن این باکتری باعث ضخامت بیشتر مخاط محافظ معده شد که مانع عبور بعضی از مواد از معده و ورود به جریان خون می شود.
این باکتری همچنین علائم شیمیایی صادر شده از دستگاه گوارشی را عوض کرد که باعث تغییراتی در شیوه پردازش چربی در بدن شد.
نتایج مشابهی با افزودن نوعی الیاف به رژیم غذایی که باعث افزایش سطح آکرمانسیا موسینیفیلا شد به دست آمد.
پروفسور کانی گفت "غیرمنتظره" است که فقط یک گونه باکتری در معده می تواند چنین تاثیری داشته باشد.
او گفت که این "اولین گام" به سوی "استفاده از این باکتری به عنوان راهی برای جلوگیری یا درمان چاقی مفرط و دیابت نوع ۲ است" و اینکه بعضی از انواع درمان باکتریایی "در آینده نزدیک" عملی خواهد شد.
البته شاید لازم به یادوری نباشد اما پروفسور کالین هیل میکروب شناس در دانشگاه کورک می گوید که قاعدتا نمی توانید تمام روز سوسیس و چیپس و بستنی بخورید و بعد انتظار داشته باشید که آنها با مصرف باکتری آب کنید.
فایده آمازون در تولید انرژی برق آبی

مطالعه تازه ای حاکیست که نابودی جنگل های آمازون می تواند تولید نیروی برق آبی را به طور قابل توجهی کاهش دهد.
نتایج این مطالعه در نشریه اقدامات آکادمی ملی علوم چاپ شده است.
بسیاری از کشورها در مناطق حاره ای درحال روی آوردن به نیروی برق آبی به عنوان یک منبع انرژی هستند.
از جمله هم اکنون در برزیل ۴۵ نیروگاه آبی در مرحله طراحی است.
جنگل های حاره ای که در اصطلاح انگلیسی جنگل های بارانی خوانده می شوند بهترین جا برای ساختن سد برای تولید برق است.
اصولا تا به حال تصور می شد که قطع درختان در نزدیکی سدها عملا میزان آب جاری به سد را افزایش می دهد.
اما در مطالعه تازه معلوم شد که این جنگل ها نقش مهمی در تولید بارندگی دارند.
دکتر کلودیا استیکلر از برنامه بین المللی موسسه تحقیقات زیست محیطی آمازون می گه که که جنگل های حاره ای باران خودشان را تولید می کنند یعنی آب را از خاک جذب و به صورت بخار در هوا منتشر می کنند.
پژوهشگران دریافتند که میزان بارندگی در آمازون به دلیل قطع درختان شش تا هفت درصد نسبت به زمانی که پوشش گیاهی منطقه کامل بود کاهش یافته است.
و پیش بینی ها حاکیست که تا سال ۲۰۵۰ ، ۴۰ درصد جنگل های منطقه از میان خواهد رفت که به معنی کاهش شدید بارندگی خواهد بود.
میزان کاهش برق تا آن زمان ۳۵ تا ۴۰ درصد تخمین زده می شود.
به این ترتیب مطالعه تازه نشان می دهد که جنگل های حاره ای نه فقط برای تنوع زیستی و جذب دی اکسید کربن اهمیت دارند، بلکه نقشی جدی در تولید انرژی دارند.
به این ترتیب حالا برزیل بهانه دیگری برای حفظ آمازون دارد.











